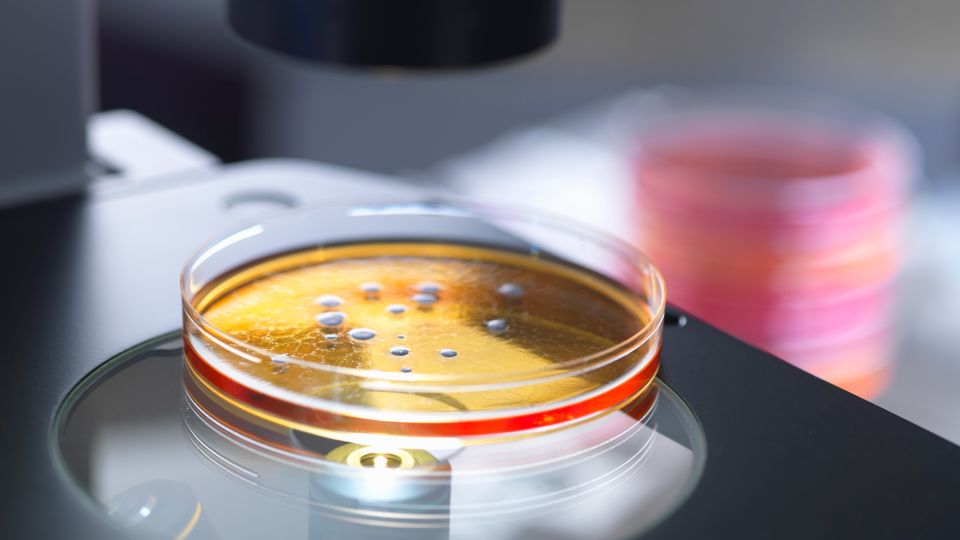

قم بالتسجيل في النشرة الإخبارية للعلوم Wonder Theory على قناة CNN. استكشف الكون بأخبار الاكتشافات الرائعة والتقدم العلمي والمزيد.
دقت مجموعة مكونة من 38 عالمًا يعملون في تسعة بلدان ناقوس الخطر بشأن احتمال إنشاء بكتيريا مرآة – وهي كائنات اصطناعية يكون فيها التركيب الجزيئي الموجود في الطبيعة معكوسًا ويمكن أن يعرض البشر والحيوانات والنباتات لخطر التعرض لمسببات الأمراض الخطيرة.
في حين أن العلم والتكنولوجيا اللازمين لإنشاء بكتيريا مرآة في المختبر لا يزال أمامنا عقد من الزمن أو أكثر، فقد جادل العلماء بأن المخاطر المميتة المحتملة التي يفرضها هذا المجال الجديد من البحث “غير مسبوقة” و”تم التغاضي عنها”.
وكتب الباحثون في تقرير نُشر في عدد 12 ديسمبر من مجلة Science: “بدافع الفضول والتطبيقات المعقولة، بدأ بعض الباحثين العمل على إنشاء أشكال حياة مكونة بالكامل من جزيئات بيولوجية ذات صورة معكوسة”.
“مثل هذه الكائنات المرآة ستشكل خروجًا جذريًا عن الحياة المعروفة، وخلقها يستحق دراسة متأنية.”
السمة الأساسية لجميع أشكال الحياة المعروفة هي عدم التناظر الموحد، أو استخدام إحدى اليدين. على سبيل المثال، يتكون الحمض النووي الريبي (DNA) والحمض النووي الريبي (RNA) من النيوكليوتيدات “اليمنية”، وتتكون البروتينات من الأحماض الأمينية “العسراوية”. مثلما لا يمكن للقفاز الأيمن أن يناسب اليد اليسرى، فإن التفاعلات بين الجزيئات غالبًا ما تعتمد على عدم التناظر.
وبينما كان المؤلفون، الذين ضموا خبراء في علم المناعة وعلم أمراض النبات والبيئة والبيولوجيا التطورية والأمن الحيوي وعلوم الكواكب، متشككين في البداية في أن البكتيريا المرآة يمكن أن تشكل مخاطر كبيرة، قال الخبراء إنهم أصبحوا الآن “قلقين للغاية”.
وقال المؤلف المشارك للتقرير جوناثان جونز، قائد المجموعة في مختبر سينسبري في نورويتش بالمملكة المتحدة: “إنه جني لا تريد أن تخرجه من القمقم”.
وأضاف: “إن خطر حدوث شيء سيء منخفض، لكن عواقب حدوث شيء سيء فظيعة حقًا”.
وما لم تظهر أدلة دامغة على أن الحياة المرآة لن تشكل مخاطر غير عادية، فلا ينبغي السماح بالأبحاث التي تهدف إلى إنشاء بكتيريا مرآة، ويجب على الممولين أن يوضحوا أنهم لن يدعموا مثل هذا العمل، كما أوصى العلماء.
مخاطر البكتيريا المرآة
استند المؤلفون في ورقتهم العلمية إلى تقرير فني مكون من 300 صفحة أصدرته مؤسسة أبحاث الجينوم غير الربحية J. Craig Venter Institute والذي شرح بالتفصيل جدوى ومخاطر البكتيريا المرآة.
وقال التقرير إن خلق حياة مرآة كان طموحًا طويل المدى للعديد من المختبرات والممولين الرئيسيين للأبحاث كجزء من الجهود الرامية إلى فهم الحياة بشكل أفضل وربما المساعدة في تطوير الأدوية والعلاجات الأخرى.
يسعى العديد من علماء الأحياء الاصطناعية إلى فهم كيفية إنشاء الخلايا من الجزيئات المكونة لها بهدف تسليط الضوء على كيفية ظهور الحياة لأول مرة وفهم أنواع الحياة الأخرى التي قد تكون ممكنة. وقال التقرير إنه إذا كان من الممكن إنشاء خلية ذات عدم انطباقية طبيعية من جزيئات هامدة، فمن الناحية النظرية، يمكن إنشاء خلية صورة مرآة من جزيئات صورة مرآة باستخدام نفس الأساليب.
وشدد التقرير على أنه لا يوجد تهديد وشيك، وتوجد حاليًا عقبات فنية كبيرة أمام تكوين البكتيريا المرآة. إن القيام بذلك في غضون عقد من الزمن سوف يتطلب جهوداً كبيرة ومنسقة مماثلة من حيث الحجم والميزانية لمشروع الجينوم البشري، الذي رسم خرائط لنحو 92% من الجينوم البشري على مدى اثني عشر عاماً ونصف.
الكائنات الحية المعرضة للعدوى
تعتمد أجهزة المناعة على التعرف على الأشكال الجزيئية المحددة الموجودة في البكتيريا الغازية. إذا انعكست هذه الأشكال – كما هو الحال في البكتيريا المرآة – فسيضعف التعرف عليها وقد تفشل الدفاعات المناعية، مما قد يترك الكائنات الحية عرضة للعدوى.
وقال العلماء في تقرير العلوم: “لا يمكننا استبعاد السيناريو الذي تعمل فيه البكتيريا المرآة كأنواع غازية عبر العديد من النظم البيئية، مما يتسبب في انتشار العدوى المميتة في جزء كبير من الأنواع النباتية والحيوانية، بما في ذلك البشر”.
“حتى البكتيريا المرآة ذات نطاق مضيف أضيق والقدرة على غزو مجموعة محدودة فقط من النظم البيئية يمكن أن تسبب ضررًا غير مسبوق وغير قابل للإصلاح.”
يمكن أن يؤدي انتقال هذه البكتيريا عن طريق الحيوانات والبشر إلى انتشار هذه البكتيريا في أنظمة بيئية مختلفة. وقال جونز، الخبير في أجهزة المناعة النباتية، إن البكتيريا المرآة سيكون من الصعب للغاية اكتشافها في النباتات.
“حتى لو لم ينمو بشكل جيد في البداية، فإن الطفرات ستبدأ وسيكون هناك اختيار لشيء ينمو بشكل أفضل. وأوضح جونز أن هذه هي الطريقة التي يعمل بها التطور.
وقال توم إليس، أستاذ هندسة الجينوم الاصطناعي في مركز البيولوجيا الاصطناعية وقسم الهندسة الحيوية التابع لكلية إمبريال كوليدج، إن الحياة المرآة لا تزال خيالًا علميًا أكثر من كونها حقيقة علمية.
وقال إليس، الذي لم يشارك في البحث: “بشكل عام، أنا أتفق مع هذه المخاوف، على الرغم من أنها تخمينية للغاية بالنظر إلى أن الأبحاث حاليًا في مرحلة مبكرة جدًا وبعيدة جدًا عن أن تشكل أي تهديد”.
وقال إليس إن العلماء كانوا يحاولون خلق حياة اصطناعية باستخدام جزيئات غير مرآة لأكثر من عقد من الزمن، لكنهم ما زالوا “بعيدين” عن امتلاك خلايا مكتفية ذاتيا يمكنها الانقسام والتكاثر والتطور.
“إن عمل “الخلية الاصطناعية” يمثل تحديًا كافيًا بالفعل عندما يستخدم (العلماء) الجزيئات والإنزيمات والمواد الكيميائية العادية. وقال عبر البريد الإلكتروني: “عندما يضطرون إلى القيام بكل ذلك ولكن باستخدام جزيئات المرآة فقط، التي يجب تصنيعها واختراعها، فإن ذلك يجعل الأمر أصعب 1000 مرة”.
لمزيد من الأخبار والنشرات الإخبارية لـ CNN، قم بإنشاء حساب على CNN.com

اترك ردك